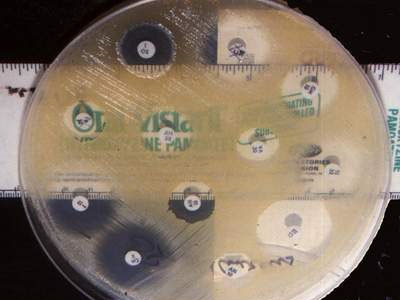
Làm kháng sinh đồ để lựa chọn kháng sinh thích hợp

Hại con vì dùng thuốc sai cách
>> Vẫn dùng thuốc nghi gây tai biến tiêm cho bệnh nhi
Hiện nay dùng kháng sinh chưa đúng và chưa hợp lý một phần do người dân mua kháng sinh còn tùy tiện, đặc biệt là dùng thuốc kháng sinh đối với trẻ em. Sử dụng kháng sinh không đúng ở trẻ em sẽ gây ra nhiều hậu quả xấu cho trẻ.
![]() |
| Làm kháng sinh đồ để lựa chọn kháng sinh thích hợp. |
Dùng kháng sinh cho trẻ luôn phải lưu ý, đặc biệt đối với trẻ nhỏ. Chúng ta biết rằng đặc điểm sinh lý của trẻ hoàn toàn khác với người trưởng thành, do đó việc dùng thuốc nói chung và thuốc kháng sinh nói riêng cho trẻ không giống như người lớn.
Tại sao phải dùng kháng sinh?
Kháng sinh bao gồm nhiều nhóm khác nhau, cơ chế tác dụng của từng nhóm lên vi khuẩn cũng khác nhau. Tuy vậy trong mỗi một nhóm kháng sinh có nhiều loại biệt dược cùng chung cơ chế tác dụng lên vi khuẩn nhưng đôi khi tác dụng không mong muốn lại không giống nhau. Muốn sử dụng một loại kháng sinh nào đó người bác sĩ khám bệnh phải biết được kháng sinh đó thuộc nhóm nào, cơ chế tác dụng của chúng ra sao (tác dụng chính và tác dụng không mong muốn - tác dụng phụ), đặc biệt khi muốn kết hợp kháng sinh.
Mặt khác liều lượng, hàm lượng của thuốc kháng sinh dùng cho trẻ cũng hoàn toàn khác so với người lớn. Vai trò của kháng sinh đã được xác định rõ là chỉ dùng trong các bệnh nhiễm trùng do vi khuẩn hoặc vi nấm. Kháng sinh còn được dùng để phòng các bệnh truyền nhiễm có nguy cơ gây thành dịch. Người ta cũng có thể dùng kháng sinh trước và sau phẫu thuật để phòng nhiễm trùng bệnh viện. Nếu dùng kháng sinh đúng, hợp lý thì bệnh sẽ chóng khỏi nhưng ngược lại khi dùng kháng sinh không hợp lý, không đúng thì sẽ rất nguy hiểm, đặc biệt đối với trẻ em.
Dùng kháng sinh cho trẻ như thế nào?
Tự ý mua kháng sinh không cần đơn thuốc của bác sĩ rất nguy hiểm cho người dùng, nhất là trẻ em. Hầu hết mọi người đều biết kháng sinh là một loại thuốc cực kỳ hữu hiệu dùng để cứu sống trẻ mỗi khi mắc bệnh nhiễm khuẩn do vi khuẩn gây nên nhưng không vì thế mà lạm dụng.
Hiện tượng tự mua thuốc kháng sinh để điều trị cho trẻ dù không biết thuốc đó là thuốc gì, nhóm nào, tác dụng ra sao và cũng không biết trẻ đang mắc bệnh gì, nghĩa là người mẹ thấy con mình có ho, hắt hơi, sổ mũi hoặc hơi sốt (người mẹ cảm nhận được do tự phán đoán) là cho dùng kháng sinh. Việc dùng kháng sinh như vậy thì bệnh không những không khỏi mà có khi còn nặng thêm và đặc biệt nguy hiểm nếu trẻ uống quá liều hoặc bị dị ứng thuốc.
Một số thuốc kháng sinh không được dùng cho trẻ nhỏ, nếu cứ tự động mua cho trẻ dùng thì sẽ lợi bất cập hại như chloramphenicol sẽ gây hội chứng xanh xám ở trẻ sơ sinh và nếu dùng kéo dài có thể gây ngộ độc cho tuỷ xương là cơ quan tạo máu. Hoặc tetracyclin không được dùng cho trẻ sơ sinh và trẻ dưới 8 tuổi. Kháng sinh nhóm aminozid như streptomycin, gentamycin nếu dùng cho trẻ sơ sinh có thể gây điếc. Hoặc việc dùng thuốc nhóm quinolon cũng phải hết sức cảnh giác với trẻ em, nhất là trẻ nhỏ do ảnh hưởng đến quá trình phát triển của sụn xương.
Vì vậy muốn biết trẻ có nên dùng thuốc kháng sinh hay không và dùng loại nào thì nhất thiết phải có ý kiến của bác sĩ, nhất là bác sĩ chuyên khoa nhi. Chỉ dùng kháng sinh cho trẻ khi bác sĩ thấy trẻ có các triệu chứng lâm sàng nhiễm khuẩn nghi do vi khuẩn (hoặc vi nấm), ví dụ có dấu hiệu viêm nhiễm như sưng, nóng, đỏ, đau trong một số bệnh viêm cơ, áp-xe cơ hoặc trong các bệnh về đường hô hấp (viêm phế quản - phổi...), trong các bệnh về tai, mũi, họng như VA, amidan, viêm tai... hoặc mắc bệnh do virut nhưng có bội nhiễm thêm vi khuẩn như viêm phế quản sau sởi, nhiễm trùng da do thủy đậu.
Ở các cơ sở y tế có điều kiện thì bác sĩ còn cho xét nghiệm xem là trẻ mắc bệnh do vi khuẩn gì và thực hiện kháng sinh đồ để lựa chọn kháng sinh thích hợp. Khi bác sĩ đã tìm ra nguyên nhân và chẩn đoán chắc chắn trẻ có mắc bệnh nhiễm khuẩn thì bác sĩ sẽ có chỉ định cụ thể dùng thuốc kháng sinh gì, mỗi ngày dùng bao nhiêu là đủ, thuốc đó dùng bằng cách nào (uống, tiêm hay đặt hậu môn).
Khi đã có đơn của bác sĩ, người mẹ cần tuân thủ dùng đúng chỉ định, tuyệt đối không tự ý đổi tên thuốc (việc này có thể gặp ở một số quầy thuốc tư nhân, dược tá muốn bán được loại thuốc mình có cho nên cứ tư vấn theo hướng đó để bệnh nhân hay người nhà bệnh nhân mua thuốc của mình bất chấp người bệnh đã có đơn của bác sĩ).
Trường hợp sử dụng kháng sinh không hoặc kém hiệu quả như do vi khuẩn đã kháng lại thuốc kháng sinh hoặc loại thuốc đó không phù hợp như uống vào buồn nôn, thậm chí bị dị ứng thì trước tiên phải ngừng ngay, không tiếp tục cho trẻ uống loại thuốc đó nữa và báo ngay cho bác sĩ đó khám bệnh và kê đơn biết để được thầy thuốc tư vấn và có hướng xử lý thích hợp.
PGS.TS. TTƯT. Bùi Khắc Hậu
Theo Sức khỏe & đời sống